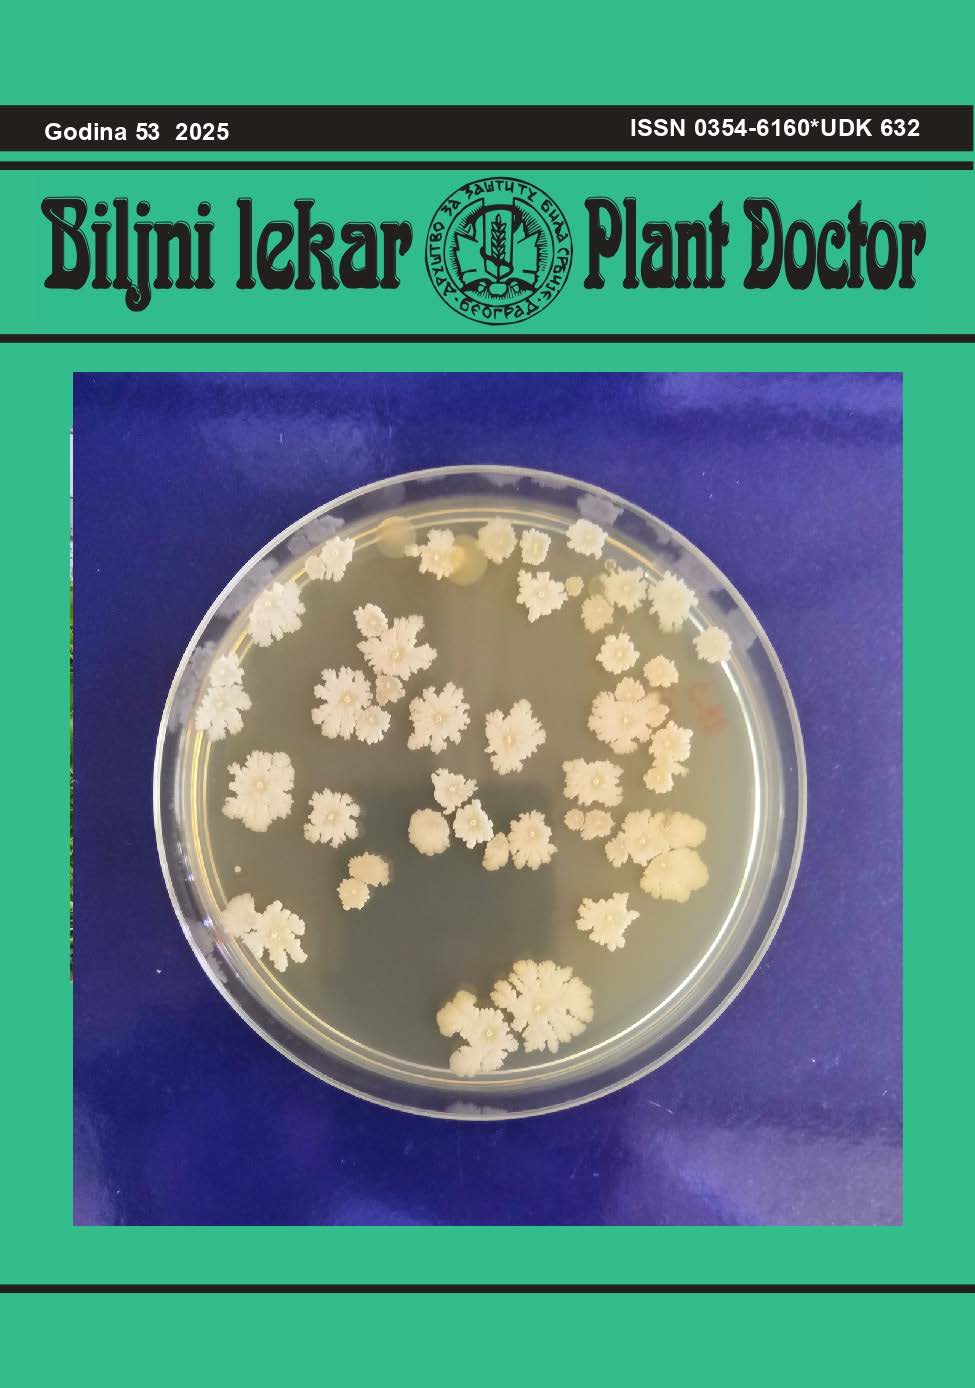

| Youtube |
|---|
:: СТУДЕНТИ нови број рачуна: 840-0000032810845-89Позиви на број остају исти као и до сада |
:: КУПЦИ нови број рачуна: 840-0000032935845-91Позив на број је исти као што је наведен на фактури |
| Неопходно је да се правилно унесу број рачуна и позив на број приликом сваке уплате. Повраћај погрешне уплате не врши више Факултет, већ Министарство финансија. |
Вести и обавештења
-
Пријава испита за aприлски испитни рок школске 2025/2026 године
24/03/2026 - 11:44 -
Oбавештење, oвера зимског семестра за школску 2025/2026 годину
11/03/2026 - 21:13 -
Бесплатна пријава испита за добровољне даваоце крви, фебруарски испитни рок школске 2025/2026 године
26/02/2026 - 12:49 -
Припремна настава за будуће студенте основних академских студија
09/03/2026 - 12:49 -
Обука за професионалне кориснике средстава за заштиту биља
31/12/2025 - 12:02 -
Јавни увид: дипломски радови иас вм и мастер радови
03/04/2026 - 11:57 -
Smotra studenata
04/03/2026 - 13:24